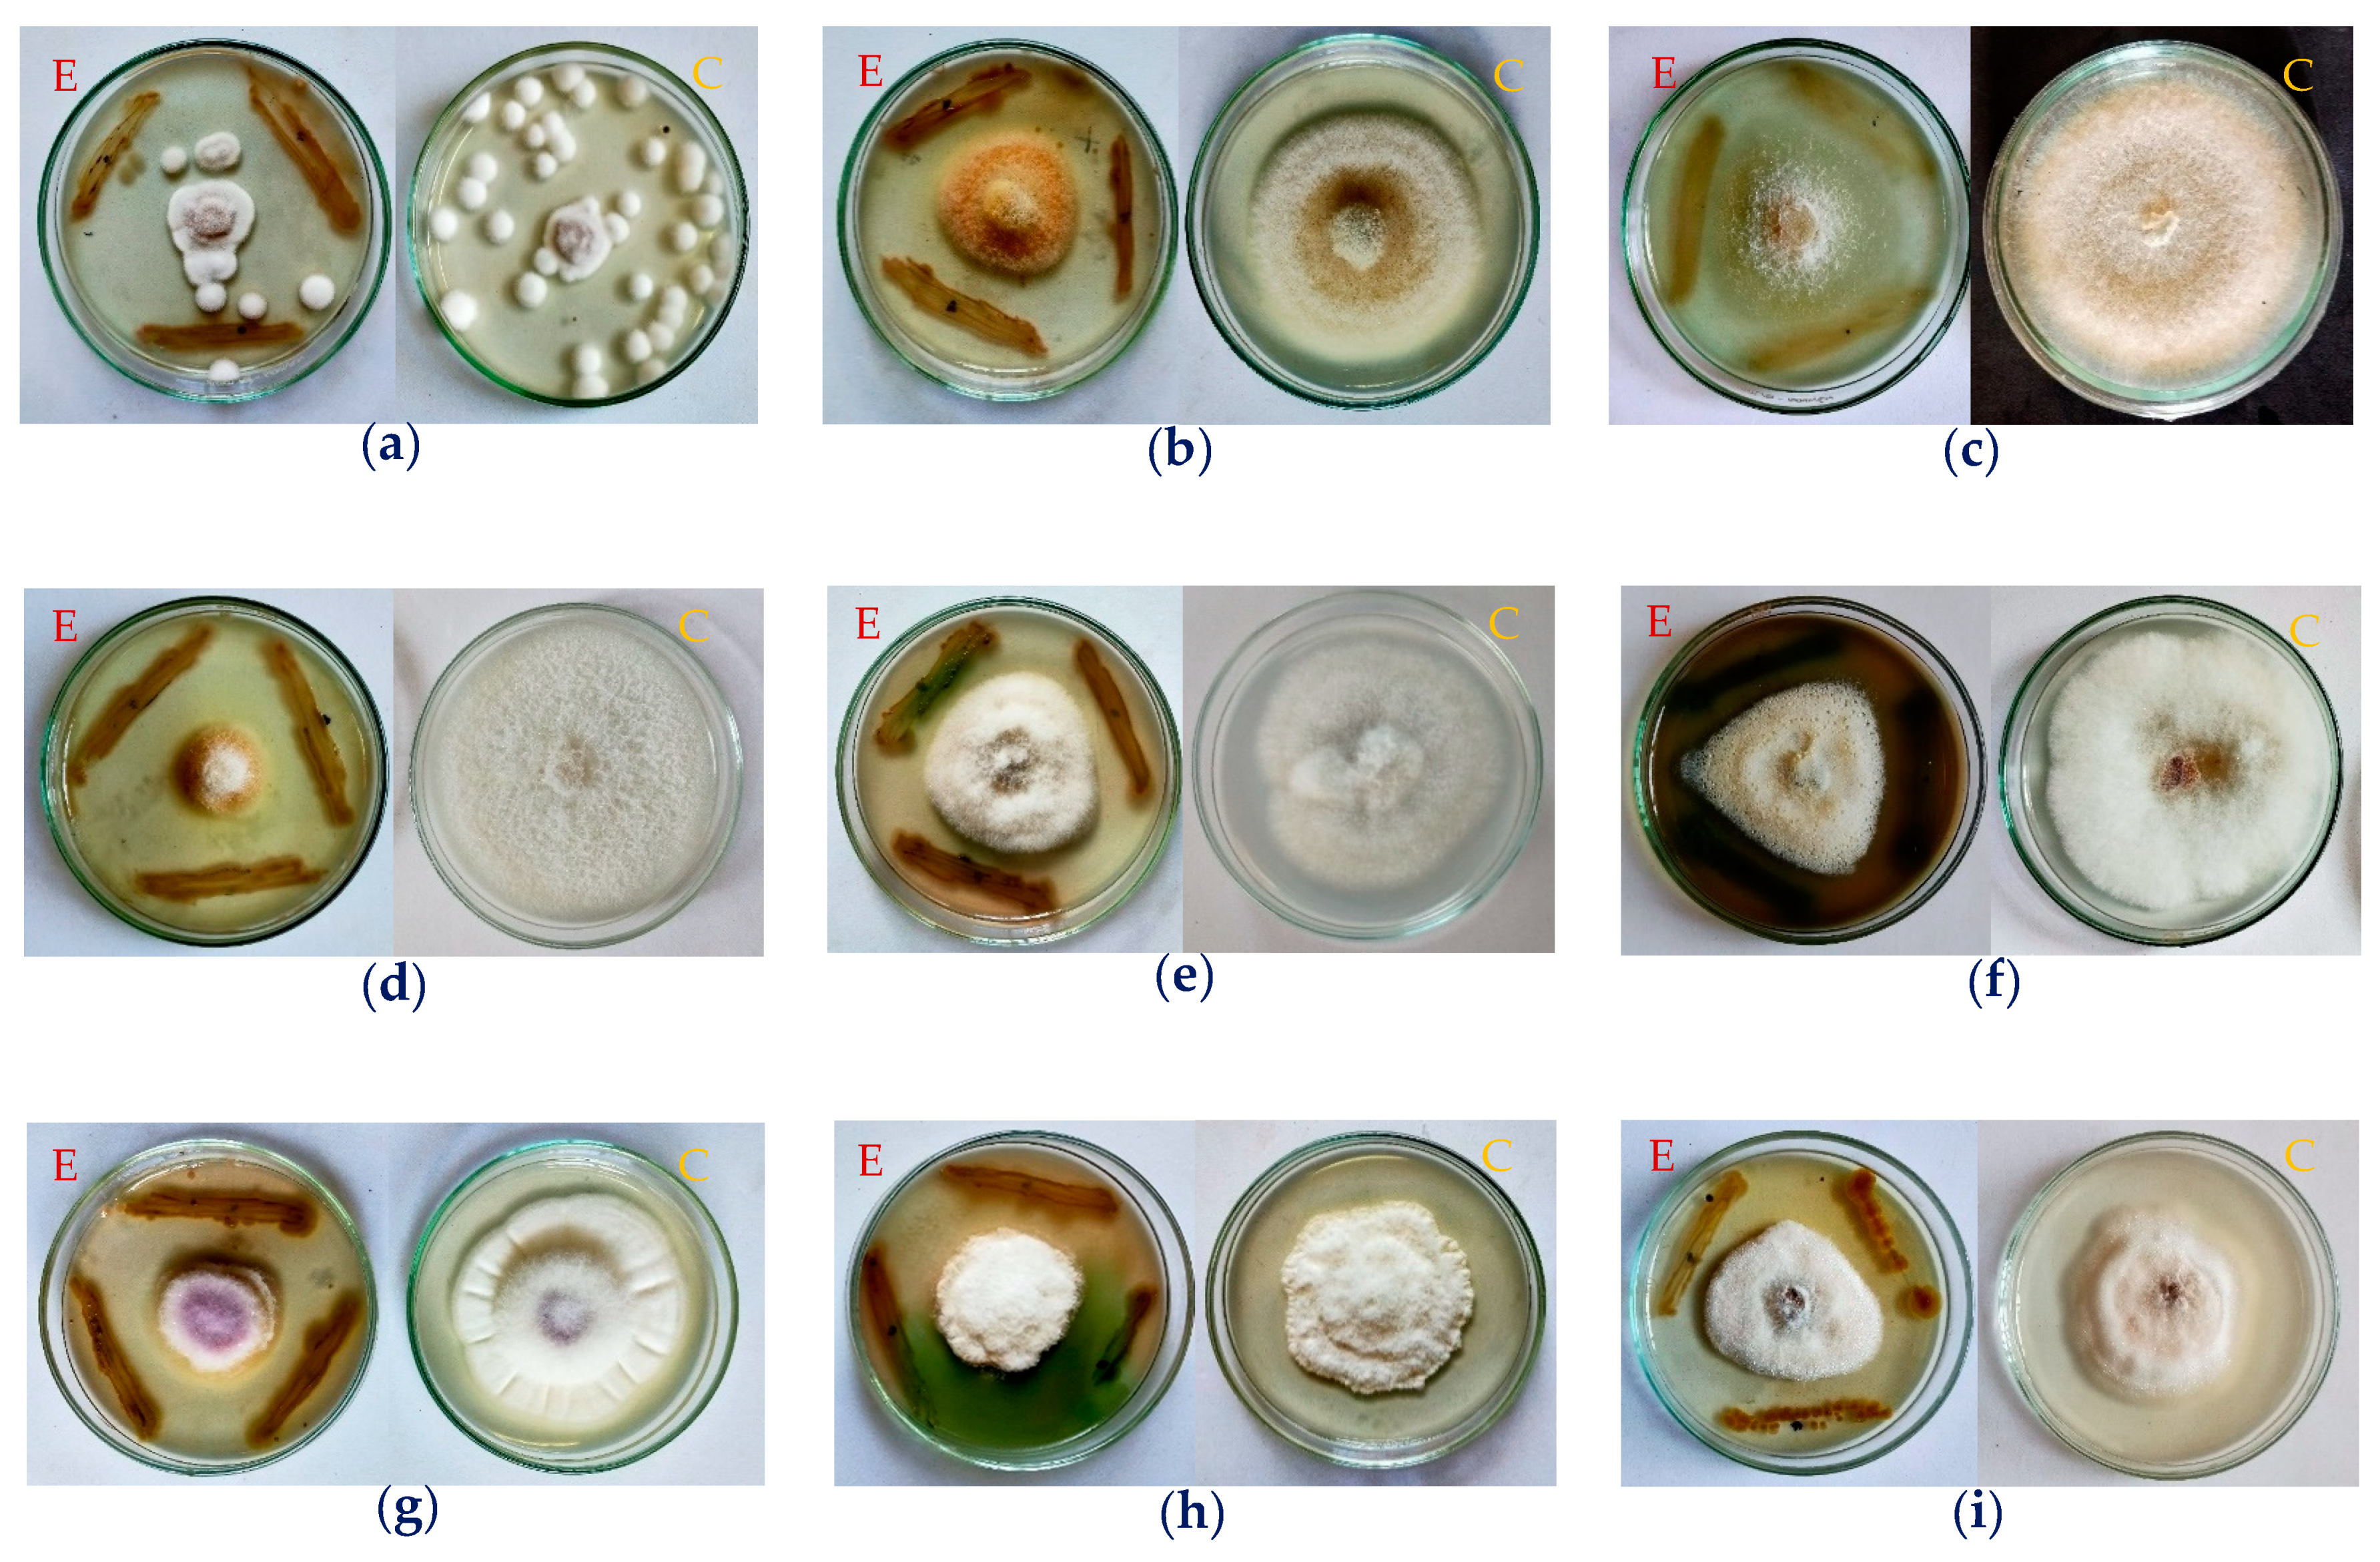

Potential Application of Rhizobacteria Isolated from the Central Highland of Vietnam as an Effective Biocontrol Agent of Robusta Coffee Nematodes and as a Bio-Fertilizer
Abstract
1. Introduction
2. Materials and Methods
2.1. Isolation and Identification of Rhizobacterial Strains from Robusta Coffee Roots
2.2. In Vitro Assay of Anti-Nematode Activity
2.3. The Effect of Rhizobacterial Strains as Anti-Nematodes and the Plant-Promoting Effect for Robusta Trees in Green Houses
- (1)
- Increased shoot, root length, and dry weight were determined by comparing the shoot, root length, and dry weight of the coffee tree after three months (B) to the initial seedling size (A) according to the equation: Increased parameters = B − A.
- (2)
- The photosynthetic pigments were examined as per the method reported by Nguyen et al. (2011) [32]. The leaves of coffee seedlings (0.5 g) were collected and cut into small pieces and immersed in 100 mL of 80% acetone for 72 h to extract the photosynthetic pigments. The extraction solvent was diluted three times and measured with a spectrophotometer at 663, 645, and 440.5 nm. The content of photosynthetic pigments was calculated using the following equations:Ca (mg/g fresh weight) = (0.0127 × OD663 − 0.00269 × OD645) × 100Cb (mg/g fresh weight) = (0.0299 × OD645 − 0.00468 × OD663) × 100where Ca, Cb (mg g−1 fresh leaf) are content of chlorophyll a and b; and Ccar (mg/g fresh weight) is carotenoid content.Ccar (mg/g fresh weight) = (0.004695 × OD440.5 − 0.000268 (Ca + Cb)) × 100
2.4. Anti-Fungal Assays
2.5. High-Performance Liquid Chromatography (HPLC) Analysis of Plant-Promoting Compounds
2.6. Statistical Analysis
3. Results and Discussion
3.1. Isolation, Evaluation, and Identification of the Most Active Anti-Nematodes Rhizobacterium via In Vitro Tests
3.2. Assessment of the Potential Biocontrol of Robusta Coffee Nematodes and Plant-Promoting Effect of Pseudomonas aeruginosa TUN03 under Greenhouse Conditions
3.3. Potential Application of P. aeruginosa TUN03 as a Potent Biofertilizer Agent Related to Large-Scale Production of Plant Growth Promoting Compounds (PGPCs)
3.4. Novel Potential Anti-Fungal Effect of Pseudomonas aeruginosa TUN03
4. Conclusions
Author Contributions
Funding
Institutional Review Board Statement
Informed Consent Statement
Data Availability Statement
Conflicts of Interest
References
- Hall, S.; Desbrow, B.; Anoopkumar-Dukie, S.; Davey, A.K.; Arora, D.; McDermott, C.; Schubert, M.M.; Perkins, A.V.; Kiefel, M.J.; Grant, G.D. A review of the bioactivity of coffee, caffeine and key coffee constituents on inflammatory responses linked to depression. Food Res. Int. 2015, 76, 626–636. [Google Scholar] [CrossRef] [PubMed]
- Trinh, P.Q.; De La Peñ, E.; Nguyen, C.N.; Nguyen, H.X.; Moens, M. Plant-parasitic nematodes associated with coffee in Vietnam. Russ. J. Nematol. 2009, 17, 73–82. [Google Scholar]
- Le, T.M.L.; Nguyen, T.D.; Nguyen, H.T.; Liebanas, G.; Nguyen, T.A.D.; Trinh, Q.P.A. New root-knot nematode, Meloidogyne moensin. sp. (nematoda: Meloidogynidae), parasitizing robusta coffee from Western Highlands, Vietnam. Helminthologia 2019, 56, 229–246. [Google Scholar] [CrossRef] [PubMed]
- Trinh, Q.P.; Le, T.M.L.; Nguyen, T.D.; Nguyen, H.T.; Liebanas, G.; Nguyen, T.A.D. Meloidogyne daklakensis n. Sp. (Nematoda: Meloidogynidae), a new root-knot nematode associated with robusta coffee (coffea canephora pierre ex a. froehner) in the Western Highlands, Vietnam. J. Helminthol. 2019, 93, 242–254. [Google Scholar] [CrossRef]
- Villain, L.; Lima, S.S.M.; Trinh, P.Q. Plant Parasitic Nematodes in Subtropical and Tropical Agriculture; Sikora, R.A., Coyne, D., Hallmann, J., Timper, P., Eds.; CABI: Wallingford, UK, 2018; pp. 536–583. [Google Scholar]
- Hoang, H.; Tran, L.H.; Nguyen, T.H.; Nguyen, D.A.T.; Nguyen, H.H.T.; Pham, N.B.; Trinh, P.Q.; de Boer, T.; Brouwer, A.; Chu, H.H. Occurrence of endophytic bacteria in Vietnamese robusta coffee roots and their effects on plant parasitic nematodes. Symbiosis 2020, 80, 75–84. [Google Scholar] [CrossRef]
- Chapman, K.R. Final Report: Collaborative Study of Coffee Rejuvenation Strategies in Vietnam–Technical Aspects; FAO: Rome, Italy, 2014. [Google Scholar]
- Nair, K.P.P. The Agronomy and Economy of Turmeric and Ginger; Elsevier: Amsterdam, The Netherlands, 2013; pp. 139–157. [Google Scholar]
- Wiratno, M.S.; Pradana, A.P.; Yousif, A.I.A. Biological control of root-knot nematode (meloidogyne spp.) in pepper plants utilizing endophytic bacteria Pseudomonas sp. AND Micrococcus sp. Focus Pepper 2018, 9, 11–22. [Google Scholar]
- Vu, A.T.; Trinh, Q.P.; Nguyen, V.T. Nematode in basalt soil replaces coffee and the relationship of nematode with yellow leaf coffee symptoms in Gia Lai. J. Agric. Dev. 2014, 23, 36–43. [Google Scholar]
- Tran, T.P.H.; Wang, S.L.; Nguyen, V.B.; Tran, D.M.; Nguyen, D.S.; Nguyen, A.D. Study of novel endophytic bacteria for biocontrol of black pepper root-knot nematodes in the Central Highlands of Vietnam. Agronomy 2019, 9, 714. [Google Scholar] [CrossRef]
- Sorribas, F.J.; Ornat, C.; Galeano, M.; Verdejo-Lucas, S. evaluation of a native and introduced isolate of pochonia chlamydosporium against Meloidogyne javania. Biocontrol. Sci. Technol. 2003, 13, 707–714. [Google Scholar] [CrossRef]
- Nguyen, V.B.; Wang, S.L.; Nguyen, T.H.; Nguyen, T.H.; Trinh, T.H.T.; Nong, T.T.; Nguyen, T.U.; Nguyen, V.N.; Nguyen, A.D. Reclamation of rhizobacteria newly isolated from black pepper plant roots as potential biocontrol agents of root-knot nematodes. Res. Chem. Intermed. 2019, 45, 5293–5307. [Google Scholar] [CrossRef]
- Wheeler, T.A.; Siders, K.T.; Anderson, M.G.; Russell, S.A.; Woodward, J.sE.; Mullinix, B.G. Management of Meloidogyne incognita with chemicals and cultivars in cotton in a semi-arid environment. J. Nematol. 2014, 46, 101–107. [Google Scholar] [PubMed]
- Borah, B.; Ahmed, R.; Hussain, M.; Phukon, P. Suppression of root-knot disease in Pogostemon cablin caused by Meloidogyne incognita in a rhizobacteria mediated activation of phenylpropanoid pathway. Biol. Control. 2018, 119, 43–50. [Google Scholar] [CrossRef]
- Nguyen, V.N.; Kim, Y.J.; Oh, K.T.; Jung, W.J.; Park, R.D. The role of chitinase from Lecanicillium antillanum b-3 in parasitism to root-knot nematode Meloidogyne incognita eggs. Biocontrol. Sci. Technol. 2007, 17, 1047–1058. [Google Scholar] [CrossRef]
- Mervat, A.A.; Shawky, S.M. Comparative efficacy of some bioagents, plant oil and plant aqueous extracts in controlling Meloidogyne incognita on growth and yield of grapevines. Ann. Agric. Sci. 2012, 57, 7–18. [Google Scholar] [CrossRef]
- Mokbel, A.A. Impact of some antagonistic organisms in controlling Meloidogyne arenaria infecting tomato plants. JOLST 2013, 1, 69–74. [Google Scholar] [CrossRef][Green Version]
- Forghani, F.; Hajihassani, A. Recent advances in the development of environmentally benign treatments to control root-knot nematodes. Front. Plant Sci. 2020, 11, 1–13. [Google Scholar] [CrossRef] [PubMed]
- Osman, H.A.; Ameen, H.H.; Mohamed, M.; Elkelany, U.S. Efficacy of integrated microorganisms in controlling root-knot nematode Meloidogyne javanica infecting peanut plants under field conditions. Bull. Natl. Res. Cent. 2020, 44, 134. [Google Scholar] [CrossRef]
- Nguyen, A.D.; Huang, C.C.; Liang, T.W.; Nguyen, V.B.; Pan, P.S.; Wang, S.L. Production and purification of a fungal chitosanase and chitooligomers from Penicillium janthinellum D4 and discovery of the enzyme activators. Carbohydr. Polym. 2014, 108, 331–337. [Google Scholar] [CrossRef] [PubMed]
- Gao, H.; Qi, G.; Yin, R.; Zhang, H.; Li, C.; Zhao, X. Bacillus cereus strain S2 shows high nematicidal activity against Meloidogyne incognita by producing sphingosine. Sci. Rep. 2016, 6, 28756. [Google Scholar] [CrossRef] [PubMed]
- Abdelnabby, H.M.; Mohamed, H.A.; Abo Aly, H.E. Nematode-antagonistic compounds from certain bacterial species. Egypt. J. Biol. Pest. Co. 2011, 21, 209–217. [Google Scholar]
- Nguyen, V.N.; Oh, I.J.; Kim, Y.J.; Kim, K.Y.; Kim, Y.C.; Park, R.D. Purification and characterization of chitinases from Paecilomyces variotii DG-3 parasitizing on Meloidogyne incognita eggs. J. Ind. Microbiol. Biotechnol. 2009, 36, 195–203. [Google Scholar] [CrossRef] [PubMed]
- Campos, V.P.; Pinho, R.S.C.; Freire, E.S. Volatiles produced by interacting microorganisms potentially useful for the control of plant pathogens. Ciênc. Agrotec. Lavras 2010, 34, 525–535. [Google Scholar] [CrossRef]
- Sohrabi, F.; Sheikholeslami, M.; Heydari, R.; Rezaee, S.; Sharifi, R. Evaluation of four rhizobacteria on tomato growth and suppression of root-knot nematode, Meloidogyne Javanica under greenhouse conditions, a pilot study. Egypt. J. Biol. Pest. Control 2018, 28, 56. [Google Scholar] [CrossRef]
- Almaghrabi, O.A.; Massoud, S.I.; Abdelmoneim, T.S. Influence of inoculation with plant growth promoting rhizobacteria (pgpr) on tomato plant growth and nematode reproduction under greenhouse conditions. Saudi. J. Biol. Sci. 2013, 20, 57–61. [Google Scholar] [CrossRef]
- Tran, M.D.; Sugimoto, H.; Nguyen, A.D.; Watanabe, T.; Suzuki, K. Identification and characterization of chitinolytic bacteria isolated from a freshwater lake. Biosci. Biotechnol. Biochem. 2018, 82, 343–355. [Google Scholar] [CrossRef]
- Khan, Z.; Kim, S.G.; Jeon, Y.H.; Khan, H.U.; Son, S.H.; Kim, Y.H. A plant growth promoting rhizobacterium, Paenibacillus polymyxa strain GBR-1, suppresses root-knot nematode. Bioresour. Technol. 2008, 99, 3016–3023. [Google Scholar] [CrossRef] [PubMed]
- Southey, J.F. Laboratory methods for work with plant and soil nematode; Ministry of Agriculture, Fisheries and Food; HMSO: London, UK, 1986; pp. 1–4. [Google Scholar]
- Cayrol, J.C.; Djian, C.; Pijarowski, L. Study of the nematocidal properties of the culture filtrate of the nematophagous fungus Paecilomyces lilacinus. Rev. Nématologie. 1989, 12, 331–336. [Google Scholar]
- Nguyen, A.D.; Vo, T.P.K.; Tran, T.D. Research on impact of chitosan oligomers on biophysical characteristics, growth, development and drought resistance of coffee. Carbohydr. Polym. 2011, 84, 751–755. [Google Scholar]
- Ngo, V.A.; Wang, S.L.; Nguyen, V.B.; Doan, C.T.; Tran, T.N.; Tran, D.M.; Tran, T.D.; Nguyen, A.D. Phytophthora antagonism of endophytic bacteria isolated from roots of black pepper (Piper nigrum L.). Agronomy 2020, 10, 286. [Google Scholar] [CrossRef]
- Zhang, X.; Xu, D.; Zhu, C.; Lundaa, T.; Scherr, K.E. Isolation and identification of biosurfactant producing and crude oil degrading Pseudomonas aeruginosa strains. Chem. Eng. J. 2012, 209, 138–146. [Google Scholar] [CrossRef]
- Purwanti, I.F.; Kurniawan, S.B.; Imron, M.F. Potential of Pseudomonas aeruginosa Isolated from aluminium-contaminated site in aluminium removal and recovery from wastewater. Environ. Technol. Innov. 2019, 15, 100422. [Google Scholar] [CrossRef]
- Zhao, F.; Yuan, M.; Lei, L.; Li, C.; Xu, X. Enhanced production of mono-rhamnolipid in Pseudomonas aeruginosa and application potential in agriculture and petroleum industry. Bioresour. Technol. 2021, 323, 124605. [Google Scholar] [CrossRef] [PubMed]
- Ashengroph, M.; Nahvi, I.; Zarkesh-Esfahani, H.; Momenbeik, F. Use of growing cells of Pseudomonas aeruginosa for synthesis of the natural vanillin via conversion of isoeugenol. Iran. J. Pharm. Res. 2011, 10, 749–757. [Google Scholar] [PubMed]
- Pornsunthorntawee, O.; Wongpanit, P.; Chavadej, S.; Abe, M.; Rujiravanit, R. Structural and physicochemical characterization of crude biosurfactant produced by Pseudomonas aeruginosa SP4 isolated from petroleum-contaminated soil. Bioresour. Technol. 2008, 99, 1589–1595. [Google Scholar] [CrossRef]
- Samanta, A.; Pal, P.; Mandal, A.; Sinha, C.; Lalee, A.; Das, M.; Kaity, S.; Mitra, D. Estimation of biosurfactant activity of an alkaline protease producing bacteria isolated from municipal solid waste. Cent. Eur. J. Exp. Biol. 2012, 1, 26–35. [Google Scholar]
- Lee, J.H.; Boyapati, G.; Song, K.B.; Rhee, S.K.; Kim, C.H. Cloning and sequence analysis of the esta gene encoding enzyme for producing (r)-β-acetylmercaptoisobutyric acid from Pseudomonas aeruginosa 1001. J. Biosci. Bioeng. 2000, 90, 684–687. [Google Scholar] [CrossRef]
- Meyer, J.M. Pyoverdines: Pigments, siderophores and potential taxonomic markers of fluorescent Pseudomonas species. Arch. Microbiol. 2000, 174, 135–142. [Google Scholar] [CrossRef]
- Uzair, B.; Kausar, R.; Bano, S.A.; Fatima, S.; Badshah, M.; Habiba, U.; Fasim, F. Isolation and molecular characterization of a model antagonistic Pseudomonas aeruginosa divulging in vitro plant growth promoting characteristics. BioMed Res. Int. 2018, 2018, 1–7. [Google Scholar] [CrossRef]
- Khalimi, K.; Suprapta, D.N. Induction of plant resistance against soyabean stunt virus using some formulations of Pseudomonas aeruginosa. J. ASSAAS 2011, 17, 98–105. [Google Scholar]
- Vleesschauwer, D.D.; Cornelis, P.; Höfte, M. Redox-active pyocyanin secreted by Pseudomonas aeruginosa 7NSK2 triggers systemic resistance to magnaporthe grisea but enhances rhizoctonia solani susceptibility in rice. MPMI 2006, 19, 1406–1419. [Google Scholar] [CrossRef]
- Kumar, R.S.; Ayyadurai, N.; Pandiaraja, P.; Reddy, A.V.; Venkateswarlu, Y.; Prakash, O.; Sakthivel, N. Characterization of antifungal metabolite produced by a new strain Pseudomonas aeruginosa PUPa3 that exhibits broad-spectrum antifungal activity biofertilizing traits. J. Appl. Microbiol. 2005, 98, 145–154. [Google Scholar] [CrossRef]
- Houshaymi, B.; Awada, R.; Kedees, M.; Soayfane, Z. Pyocyanin, a metabolite of Pseudomonas aeruginosa, exhibits antifungal drug activity through inhibition of a pleiotropic drug resistance subfamily FgABC3. Drug Res. 2019, 69, 658–664. [Google Scholar] [CrossRef] [PubMed]
- Audenaert, K.; Pattery, T.; Cornelis, P.; Höfte, M. Induction of systemic resistance to botrytis cinerea in tomato by Pseudomonas aeruginosa 7NSK2: Role of salicylic acid, pyochelin, and pyocyanin. MPMI 2002, 15, 1147–1156. [Google Scholar] [CrossRef] [PubMed]
- Saleem, H.; Mazhar, S.; Syed, Q.; Javed, M.Q.; Adnan, A. Bio-characterization of food grade pyocyanin bio-pigment extracted from chromogenic Pseudomonas species found in pakistani native flora. Arab. J. Chem. 2021, 14, 103005. [Google Scholar] [CrossRef]
- Hegazy, M.I.; Salama, A.S.A.; El-Ashry, R.M.; Othman, A.E.I. Serratia marcescens and Pseudomonas aeruginosa are promising candidates as biocontrol agents against root-knot nematodes (Meloidogyne spp.). Middle East J. Agric. Res. 2019, 8, 828–838. [Google Scholar]
- Siddiqui, I.A.; Haque, S.A. Suppression of the root rot–root knot disease complex by Pseudomonas aeruginosa in tomato: The influence of inoculum density, nematode populations, moisture and other plant-associated bacteria. Plant. Soil. 2001, 237, 81–89. [Google Scholar] [CrossRef]
- Afzal, S.; Tariq, S.; Sultana, V.; Ara, J.; Syed, E.H. Managing the root diseases of okra with endo-root plant growth promoting Pseudomonas and Trichoderma viride associated with healthy okra roots. Pak. J. Bot. 2013, 45, 1455–1460. [Google Scholar]
- Mavrodi, D.V.; Bonsall, R.F.; Delaney, S.M.; Soule, M.J.; Phillips, G.; Thomashow, L.S. Functional analysis of genes for biosynthesis of pyocyanin and phenazine-1-carboxamide from Pseudomonas aeruginosa PAO1. J. Bacteriol. 2001, 183, 6454–6465. [Google Scholar] [CrossRef]
- Jayaseelan, S.; Ramaswamy, D.; Dharmaraj, S. Pyocyanin: Production, applications, challenges and new insights. World J. Microbiol. Biotechnol. 2014, 30, 1159–1168. [Google Scholar] [CrossRef]
- Walker, T.S.; Bais, H.P.; Grotewold, E.; Vivanco, J.M. Root exudation and rhizosphere biology. Plant Physiol. 2003, 132, 44–51. [Google Scholar] [CrossRef] [PubMed]
- Akinrinlola, R.J.; Yuen, G.Y.; Drijber, R.A.; Adesemoye, A.O. Evaluation of Bacillus strains for plant growth promotion and predictability of efficacy by in vitro physiological traits. Int. J. Microbiol. 2018, 2018, 5686874. [Google Scholar] [CrossRef] [PubMed]
- Trinh, T.H.T.; Wang, S.L.; Nguyen, V.B.; Tran, M.D.; Doan, C.T.; Vo, T.P.K.; Huynh, V.Q.; Nguyen, A.D. A potent antifungal rhizobacteria Bacillus velezensis RB.DS29 isolated from black pepper (Piper nigrum L.). Res. Chem. Intermed. 2019, 45, 5309–5323. [Google Scholar] [CrossRef]
- Nguyen, A.D.; Wang, S.L.; Trinh, T.H.T.; Tran, T.N.; Nguyen, V.B.; Doan, C.T.; Huynh, V.Q.; Vo, T.P.K. Plant growth promotion and fungal antagonism of endophytic bacteria for the sustainable production of black pepper (Piper nigrum L.). Res. Chem. Intermed. 2019, 45, 5325–5339. [Google Scholar] [CrossRef]
- Devnath, P.; Uddin, M.K.; Ahamed, F.M.M.; Hossain, M.T.; Manchur, M.A. Extraction, purification and characterization of pyocyanin produced by Pseudomonas aeruginosa. Int. Res. J. Biol. Sci. 2017, 6, 1–7. [Google Scholar]
- Qi, G.; Pan, Z.; Andriamanohiarisoamanana, F.J.; Yamashiro, T.; Iwasaki, M.; Kawamoto, K.; Umetsu, K. Isolation and characterization of plant growth promoting bacteria (PGPB) from anaerobic digestate and their effect on common wheat (triticum aestivum) seedling growth. Int. J. Environ. Agric. Res. 2017, 3, 46–52. [Google Scholar] [CrossRef]
- Hariprasad, P.; Chandrashekar, S.; Singh, S.B.; Niranjana, S.R. Mechanisms of plant growth promotion and disease suppression by Pseudomonas aeruginosa strain 2apa. J. Basic Microbiol. 2014, 54, 792–801. [Google Scholar] [CrossRef] [PubMed]
- Biswas, J.K.; Mondal, M.; Rinklebe, J.; Sarkar, S.K.; Chaudhuri, P.; Rai, M.; Shaheen, S.M.; Song, H.; Rizwan, M. Multi-metal resistance and plant growth promotion potential of a wastewater bacterium Pseudomonas aeruginosa and its synergistic benefits. Environ. Geochem. Health 2017, 39, 1583–1593. [Google Scholar] [CrossRef]
- Oves, M.; Khan, M.S.; Zaidi, A. Chromium reducing and plant growth promoting novel strain Pseudomonas aeruginosa OSG41 enhance chickpea growth in chromium amended soils. Eur. J. Soil Biol. 2013, 56, 72–83. [Google Scholar] [CrossRef]
- Bano, N.; Musarrat, J. Characterization of a new Pseudomonas aeruginosa strain NJ-15 as a potential biocontrol agent. Curr. Microbiol. 2003, 46, 324–328. [Google Scholar] [CrossRef]
- Tiwari, P.; Singh, J.S. A plant growth promoting rhizospheric Pseudomonas aeruginosa strain inhibits seed germination in Triticum aestivum (L) and Zea mays (L). Microbiol. Res. 2017, 8, 73–79. [Google Scholar] [CrossRef]
- Yasmin, S.; Hafeez, F.Y.; Mirza, M.S.; Rasul, M.; Arshad, H.M.I.; Zubair, M.; Iqbal, M. biocontrol of bacterial leaf blight of rice and profiling of secondary metabolites produced by rhizospheric Pseudomonas aeruginosa BRp3. Front. Microbiol. 2017, 8, 1895. [Google Scholar] [CrossRef]
- Chopra, A.; Bobate, S.; Rahi, P.; Banpurkar, A.; Mazumder, P.B.; Satpute, S. Pseudomonasaeruginosa RTE4: A tea rhizobacterium with potential for plant growth promotion and biosurfactant production. Front. Bioeng. Biotechnol. 2020, 8, 861. [Google Scholar] [CrossRef] [PubMed]
- Sandilya, S.P.; Bhuyan, P.M.; Nageshappa, V.; Gogoi, D.K.; Kardong, D. Impact of Pseudomonas aeruginosa MAJ PIA03 affecting the growth and phytonutrient production of castor, a primary host-plant of samia ricini. J. Soil Sci. Plant Nutr. 2017, 17, 499–514. [Google Scholar] [CrossRef]
- Ghosh, D.; Gupta, A.; Mohapatra, S. A comparative analysis of exopolysaccharide and phytohormone secretions by four drought-tolerant rhizobacterial strains and their impact on osmotic-stress mitigation in arabidopsis thaliana. World J. Microbiol. Biotechnol. 2019, 35, 90. [Google Scholar] [CrossRef] [PubMed]
- Sharma, S.; Sharma, A.; Kaur, M. Extraction and evaluation of gibberellic acid from pseudomonas sp.: Plant growth promoting rhizobacteria. J. Pharmacogn. Phytochem. 2018, 7, 2790–2795. [Google Scholar]
- Linu, M.S.; Asok, A.K.; Thampi, M.; Sreekumar, J.; Jisha, M.S. Plant growth promoting traits of indigenous phosphate solubilizing Pseudomonas aeruginosa isolates from chilli (Capsicumannuum L.) rhizosphere. Commun. Soil Sci. Plant Anal. 2019, 50, 444–457. [Google Scholar] [CrossRef]
- Sharma, P.; Verma, P.P.; Kaur, M. Phytohormones production and phosphate solubilization capacities of fluorescent Pseudomonas sp. isolated from shimla dist. of himachal pradesh. Int. J. Curr. Microbiol. Appl. Sci. 2017, 6, 2447–2454. [Google Scholar] [CrossRef][Green Version]
- Parvin, W.; Othman, R.; Jaafar, H.; Rahman, M.; Yun, W.M. chromatographic detection of phytohormones from the bacterial strain UPMP3 of Pseudomonas aeruginosa and UPMB3 of Burkholderia cepacia and their role in oil palm seedling growth. Int. J. Biotechnol. Res. 2015, 3, 73–80. [Google Scholar]

| No | Sample ID | Nematicidal Activity (%) | |
|---|---|---|---|
| Mortality of J2 Nematodes | Inhibition Against Egg Hatch | ||
| 1 | TUN01 | 87.38 ± 0.72 d | 66.07 ± 0.43 fg |
| 2 | TUN03 | 98.26 ± 0.21 a | 84.03 ± 0.90 a |
| 3 | TUN07 | 64.92 ± 0.98 kl | 77.70 ± 1.02 b |
| 4 | TUN11 | 71.98 ± 1.31 hi | 44.95 ± 2.12 j |
| 5 | TUN22 | 89.06 ± 1.42 cd | 36.50 ± 0.46 l |
| 6 | TUN31 | 69.21 ± 1.78 ij | 70.04 ± 1.02 de |
| 7 | TUN45 | 89.68 ± 0.57 cd | 69.25 ± 1.84 e |
| 8 | TUN47 | 66.40 ± 0.25 jk | 37.44 ± 0.48 kl |
| 9 | TUN66 | 78.59 ± 1.25 f | 65.48 ± 0.41 gh |
| 10 | TUN67 | 92.36 ± 1.20 bc | 69.47 ± 0.72 e |
| 11 | TUN85 | 94.45 ± 0.69 b | 72.83 ± 1.36 cd |
| 12 | TUN99 | 68.44 ± 2.04 jk | 35.80 ± 0.92 l |
| 13 | TUN108 | 77.88 ± 0.44 fg | 43.39 ± 0.42 j |
| 14 | TUN121 | 83.38 ± 1.49 e | 68.23 ± 0.29 fg |
| 15 | TUN145 | 89.21 ± 0.54 cd | 74.39 ± 1.74 c |
| 16 | TUN147 | 66.51 ± 0.25 jk | 43.88 ± 0.68 j |
| 17 | TUN169 | 74.31 ± 1.24 gh | 35.13 ± 1.47 l |
| 18 | TUN178 | 88.69 ± 1.49 cd | 68.73 ± 1.25 ef |
| 19 | TUN179 | 65.35 ± 2.24 kl | 45.73 ± 1.23 j |
| 20 | TUN184 | 60.01 ± 0.35 m | 39.65 ± 1.15 k |
| 21 | TUN198 | 75.71 ± 1.31 gh | 55.57 ± 0.39 i |
| 22 | TUN199 | 77.83 ± 1.55 fg | 62.90 ± 0.88 h |
| 23 | TUN203 | 61.85 ± 1.88 lm | 37.64 ± 0.77 kl |
| 24 | TUN205 | 89.20 ± 0.76 cd | 71.24 ± 1.41 de |
| F Value | 85.27 | 248.82 | |
| Pr > F | <0.0001 | <0.0001 | |
| P | 0.05 | 0.05 | |
| CV% | 2.753726 | 3.061748 | |
| Treatments Group | Nematodes in Rhizosphere Soils | Nematodes in Coffee Roots | DR * (%) | ||
|---|---|---|---|---|---|
| Nematodes J2 in 10 g Soil (Count) | Reduction (%) | Nematodes J2 in 1 g Root (Count) | Reduction (%) | ||
| Group 1 (negative control) | 22.0 ± 1.53 c | - | 17.7 ± 2.33 c | - | 8.2 ± 1.42 c |
| Group 2 (positive control) | 156.7 ± 8.82 a | - | 48.4 ± 4.31 a | - | 37.3 ± 3.71 a |
| Group 3 | 58.3 ± 4.41 b | 58.3 ± 3.15 | 28.7 ± 2.19 b | 28.9 ± 5.42 | 18.3 ± 1.67 b |
| Group 4 | 29.7 ± 4.84 c | 78.8 ± 3.46 | 23.1 ± 2.63 bc | 42.7 ± 6.51 | 8.3 ± 1.67 c |
| Group 5 | 23.7 ± 2.96 c | 83.1 ± 2.12 | 19.3 ± 0.333 c | 52.1 ± 0.83 | 7.7 ± 2.03 c |
| F Value | 148.85 | - | 19.48 | - | 30.62 |
| Pr > F | <0.0001 | - | 0.0003 | <0.0001 | |
| P | 0.05 | 0.05 | 0.05 | ||
| CV% | 13.94488 | - | 17.83826 | - | 24.99341 |
| LSD | 15.246 | - | 9.2175 | - | 7.5137 |
| Treatments Group | Promoting Shoots | Promoting Roots | ||
|---|---|---|---|---|
| Increased Length (cm) | Increased DW (g/10 Trees) | Increased Length (cm) | Increased DW (g/10 Trees) | |
| Group 1 (negative control) | 35.0 ± 2.89 bc | 19.8 ± 2.89 c | 16.5 ± 1.44 a | 22.5 ± 1.82 b |
| Group 2 (positive control) | 28.7 ± 2.404 c | 17.6 ± 1.48 c | 16.3 ± 1.88 a | 20.6 ± 2.80 b |
| Group 3 | 44.3 ± 2.85 ab | 28.8 ± 3.89 b | 16.8 ± 1.07 a | 30.2 ± 2.23 a |
| Group 4 | 47.7 ± 2.61 a | 34.1 ± 2.37 a | 17.1 ± 1.82 a | 30.9 ± 1.44 a |
| Group 5 | 48.1 ± 3.93 a | 32.6 ± 2.59 a | 17.0 ± 1.73 a | 30.4 ± 1.46 a |
| F Value | 6.95 | 69.75 | 1.11 | 68.56 |
| Pr > F | 0.0102 | <0.0001 | 0.4160 | <0.0001 |
| P | 0.05 | 0.05 | 0.05 | 0.05 |
| CV% | 13.82137 | 5.838377 | 3.493248 | 3.865095 |
| LSD | 10.607 | 2.9213 | 1.1019 | 1.958 |
| Treatments Group | Content of Photosynthetic Pigments (mg/g Fresh Weight) | ||
|---|---|---|---|
| Chlorophyll a | Chlorophyll b | Carotenoid | |
| Group 1 (negative control) | 0.84 ± 0.087 c | 0.51 ± 0.023 d | 0.413 ± 0.022 c |
| Group 2 (positive control) | 0.57 ± 0.073 c | 0.35 ± 0.026 e | 0.337 ± 0.026 d |
| Group 3 | 0.94 ± 0.088 b | 0.54 ± 0.033 c | 0.480 ± 0.012 c |
| Group 4 | 1.22 ± 0.093 a | 0.73 ± 0.032 a | 0.557 ± 0.012 a |
| Group 5 | 1.19 ± 0.116 a | 0.70 ± 0.029 b | 0.550 ± 0.029 ab |
| F Value | 6.87 | 764.32 | 17.86 |
| Pr > F | 0.0106 | <0.0001 | 0.0005 |
| P | 0.05 | 0.05 | 0.05 |
| CV% | 18.63119 | 1.724079 | 8.199466 |
| LSD | 0.3335 | 0.0184 | 0.0721 |
| Strains | PGPCs | Yield (µg/mL) | Medium | References |
|---|---|---|---|---|
| P. aeruginosa TUN03 | IAA | 231 | King B | This study |
| GA3 | 2702 | King B | ||
| Kinetin | 36.8 | King B | ||
| Zeatin | 7.71 | King B | ||
| P. aeruginosa Tad-21 | IAA | 24.54 | LB + Tryp | [59] |
| P. aeruginosa 2apa | IAA | 4.9 | King B | [60] |
| P. aeruginosa PUPa3 | IAA | 26.6 | LB + Tryp | [61] |
| P. aeruginosa OSG41 | IAA | 32 | LB + Tryp | [62] |
| P. aeruginosa NJ-15 | IAA | 20 | NB + Tryp | [63] |
| P. aeruginosa | IAA | 13.2 | LB + Tryp | [64] |
| P. aeruginosa BRp3 | IAA | 30 | LB | [65] |
| P. aeruginosa RTE4 | IAA | 74.54 | Mannitol + Tryp | [66] |
| P. aeruginosa MAJ PIA03 | IAA | 27.84 | PIA | [67] |
| P. aeruginosa ZNP1 | IAA | 15 | PIA | [67] |
| P. aeruginosa ZNP1 | IAA | 15 | LB | [68] |
| P. aeruginosa An-1-kul | GA3 | 485.8 | King B | [69] |
| P. aeruginosa An-13-kul | GA3 | 419.2 | King B | [69] |
| P. aeruginosa MAJ PIA03 | GA3 | 8.21 | PIA | [67] |
| P. aeruginosa PM389 | GA3 | 7.5 | LB | [68] |
| P. aeruginosa PS 3 | Cytokinin | 2.96 | King B | [70] |
| P. aeruginosa PS 2 | Cytokinin | 1.32 | King B | [70] |
| Pseudomonas sp-M | Cytokinin | 30 | King B | [71] |
| P. aeruginosa PM389 | Trans-Zeatin | 12 | LB | [68] |
| P. aeruginosa UPMP3 | Zeatin | TLC detection | NB + Tryp | [72] |
| No | Fungal Strains | Fungal Origin |
Anti-Fungal Activity (%) |
|---|---|---|---|
| 1 | P. lilacinum F01 | Dimocarpus roots | + |
| 2 | F. solani F02 | Durio roots | 41.67 ± 0.58 d |
| 3 | F. solani F03 | Pepper roots | 30.66 ± 0.90 f |
| 4 | F. solani F04 | Coffee roots | 70.51 ± 2.56 a |
| 5 | C. gloeosporioides F05 | Sweet potato roots | 30.00 ± 0.88 g |
| 6 | F. incarnatum F06 | Citrus roots | 44.15 ± 1.92 c |
| 7 | G. butleri F07 | Pepper roots | 50.00 ± 1.33 b |
| 8 | P.mangiferae F08 | Persea americana roots | 35.19 ± 1.06 e |
| 9 | F. incarnatum F09 | Hylocereus undatus roots | 15.09 ± 0.36 j |
| 10 | F. oxysporum F10 | Pepper roots | 0.00 ± 0.00 k |
| 11 | Neonectria sp. F11 | Durio fruits | 20.50 ± 0.53 i |
| 12 | F. incarnatum F15 | Knotweed leaves | 28.57 ± 0.35 h |
| F Value | 10,751.3 | ||
| Pr > F | <0.0001 | ||
| P | 0.05 | ||
| CV% | 0.938284 | ||
Publisher’s Note: MDPI stays neutral with regard to jurisdictional claims in published maps and institutional affiliations. |
© 2021 by the authors. Licensee MDPI, Basel, Switzerland. This article is an open access article distributed under the terms and conditions of the Creative Commons Attribution (CC BY) license (https://creativecommons.org/licenses/by/4.0/).
Share and Cite
Nguyen, D.N.; Wang, S.-L.; Nguyen, A.D.; Doan, M.D.; Tran, D.M.; Nguyen, T.H.; Ngo, V.A.; Doan, C.T.; Tran, T.N.; Do, V.C.; et al. Potential Application of Rhizobacteria Isolated from the Central Highland of Vietnam as an Effective Biocontrol Agent of Robusta Coffee Nematodes and as a Bio-Fertilizer. Agronomy 2021, 11, 1887. https://doi.org/10.3390/agronomy11091887
Nguyen DN, Wang S-L, Nguyen AD, Doan MD, Tran DM, Nguyen TH, Ngo VA, Doan CT, Tran TN, Do VC, et al. Potential Application of Rhizobacteria Isolated from the Central Highland of Vietnam as an Effective Biocontrol Agent of Robusta Coffee Nematodes and as a Bio-Fertilizer. Agronomy. 2021; 11(9):1887. https://doi.org/10.3390/agronomy11091887
Chicago/Turabian StyleNguyen, Dai Nam, San-Lang Wang, Anh Dzung Nguyen, Manh Dung Doan, Dinh Minh Tran, Thi Huyen Nguyen, Van Anh Ngo, Chien Thang Doan, Thi Ngoc Tran, Van Chung Do, and et al. 2021. "Potential Application of Rhizobacteria Isolated from the Central Highland of Vietnam as an Effective Biocontrol Agent of Robusta Coffee Nematodes and as a Bio-Fertilizer" Agronomy 11, no. 9: 1887. https://doi.org/10.3390/agronomy11091887
APA StyleNguyen, D. N., Wang, S.-L., Nguyen, A. D., Doan, M. D., Tran, D. M., Nguyen, T. H., Ngo, V. A., Doan, C. T., Tran, T. N., Do, V. C., & Nguyen, V. B. (2021). Potential Application of Rhizobacteria Isolated from the Central Highland of Vietnam as an Effective Biocontrol Agent of Robusta Coffee Nematodes and as a Bio-Fertilizer. Agronomy, 11(9), 1887. https://doi.org/10.3390/agronomy11091887

